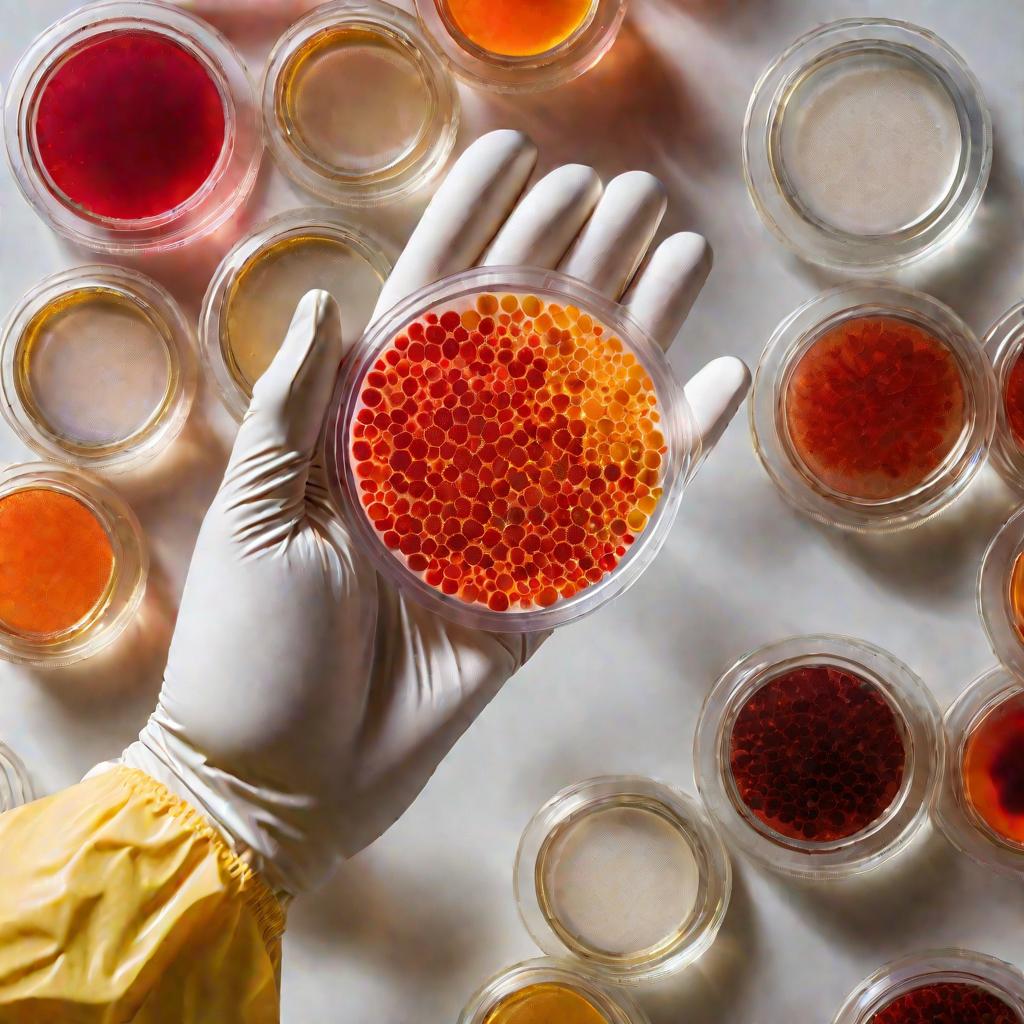
Чашка Петри с бактериями под микроскопом

Что может быть важнее здоровья? К сожалению, в современных условиях угрозы подстерегают нас повсюду - от вредных продуктов до опасных вирусов и бактерий. Как же защитить себя и близких? Ответ прост - нужно знать, как работает СЭС. В этой статье мы разберемся, что представляет собой эта служба и какие задачи она выполняет.
История возникновения и развития СЭС
Санитарно-эпидемиологическая служба (СЭС) существует в нашей стране уже более 100 лет. Потребность в такой службе возникла еще в XIX веке в связи с развитием промышленности, ростом городов и увеличением рисков распространения инфекционных заболеваний.
Первые санитарные врачи появились в России в 1892 году в Москве и Санкт-Петербурге. Их задачей был надзор за санитарным состоянием городов, борьба с эпидемиями.
В советский период санитарно-эпидемиологическая служба получила широкое развитие. Была создана разветвленная сеть санитарно-эпидемиологических станций на всей территории СССР. Они занимались профилактикой инфекционных заболеваний, контролем качества воды, продуктов, условий труда и быта населения.

Реформы СЭС в 1990-2000-е годы
После распада СССР санитарно-эпидемиологическая служба была реформирована. В 1991 году был принят закон РФ "О санитарно-эпидемиологическом благополучии населения", определивший правовые основы деятельности СЭС.
Важной вехой стало создание в 2004 году Федеральной службы по надзору в сфере защиты прав потребителей и благополучия человека (Роспотребнадзор), в ведение которого перешли все СЭС. Это позволило усовершенствовать их работу.
Структура и устройство СЭС
Существуют как государственные, так и частные СЭС. Государственные находятся в ведении Роспотребнадзора и работают в каждом регионе страны. Частные СЭС не наделены контрольно-надзорными функциями, но могут оказывать услуги по дератизации, дезинфекции и другие.
Организационная структура
СЭС имеет четкую иерархическую структуру. Во главе стоит главный санитарный врач России, возглавляющий Центральную СЭС в Москве. Ему подчиняются руководители региональных СЭС. В составе каждой СЭС работают различные отделы и лаборатории.
Как устроена СЭС внутри
В штат санэпидемстанции входят:
- Врачи-эпидемиологи
- Дезинфекторы
- Лаборанты
- Инженеры
- Юристы
- Другие специалисты
Обязательным элементом является собственная аккредитованная лаборатория для исследований.
Региональные СЭС
В каждом регионе России действует территориальное управление Роспотребнадзора и региональная СЭС. Они координируют свою деятельность с центральным аппаратом и местными органами власти.
Как найти "свою" СЭС
Чтобы найти СЭС по месту жительства, достаточно ввести в поисковике "СЭС + название города". Контакты обычно есть на официальном сайте. Можно также обратиться в районную администрацию.
Функции и задачи СЭС
Основными направлениями работы СЭС являются:
- Лабораторный контроль за средой обитания, продуктами питания, водой
- Мониторинг заболеваемости населения
- Разработка санитарных норм и гигиенических нормативов
- Проведение проверок и выдача предписаний
- Участие в противоэпидемических мероприятиях
Рассмотрим подробнее основные функции и задачи, которые выполняет эта служба.
Лабораторный контроль и мониторинг
СЭС осуществляет лабораторный контроль за состоянием окружающей среды, качеством питьевой воды, продовольственными товарами, условиями труда и быта. Проводятся замеры вредных веществ, исследования на наличие инфекций и т.д.
Также СЭС отслеживает заболеваемость населения, в том числе на основании данных лечебных учреждений. Это позволяет выявлять очаги инфекций и оперативно реагировать.
Проверки организаций и предприятий
Одна из главных функций СЭС - проведение плановых и внеплановых проверок на предприятиях, в учреждениях, местах массового скопления людей. Цель - контроль за соблюдением санитарных норм и правил, выявление нарушений.
Разработка санитарных норм
Специалисты СЭС участвуют в разработке санитарно-эпидемиологических правил, гигиенических нормативов, например, предельно допустимых концентраций вредных веществ в воздухе, воде и т.д. Эти нормы носят обязательный характер.
Участие в противоэпидемических мероприятиях
При возникновении угрозы эпидемии СЭС координирует комплекс противоэпидемических мероприятий: установление карантина, дезинфекцию, вакцинацию, распространение информации и другие меры.
Просвещение и информирование населения
СЭС регулярно информирует население о складывающейся санитарно-эпидемиологической обстановке, мерах профилактики инфекционных заболеваний, правилах личной гигиены и т.д. Это важная просветительская функция.
Контроль рекламы и маркировки продукции
Еще одна важная функция СЭС - контроль рекламы и маркировки пищевой продукции, лекарственных средств, изделий медицинского назначения, косметических товаров и другой продукции. Специалисты проверяют, чтобы реклама не вводила потребителей в заблуждение, а маркировка содержала полную и достоверную информацию о товаре.
Полномочия и права СЭС
Для выполнения своих функций санитарно-эпидемиологическая служба наделена определенными полномочиями и правами.
В частности, СЭС имеет право:
- Проводить проверки организаций и граждан;
- Отбирать для исследований пробы объектов внешней среды, продуктов питания и других;
- Накладывать штрафы за нарушение санитарных норм;
- Приостанавливать деятельность организаций, представляющую опасность для здоровья;
- Давать предписания об устранении выявленных нарушений.
Эти и другие полномочия закреплены в федеральном законодательстве, что позволяет СЭС эффективно выполнять возложенные на нее задачи.
Как проходит проверка СЭС
Проверки СЭС бывают плановыми и внеплановыми. Плановые проводятся с периодичностью раз в 3 года на основании ежегодных планов. Внеплановые назначаются при поступлении жалоб, требований прокуратуры и в иных случаях.
Этапы проверки
Проверка СЭС обычно включает следующие этапы:
- Уведомление о предстоящей проверке;
- Предъявление документов, удостоверяющих личность и полномочия проверяющих;
- Осмотр территорий и помещений;
- Отбор проб для исследований;
- Анализ документации;
- Составление акта по результатам проверки.
Права проверяющих и проверяемых
Во время проверки у инспекторов СЭС и проверяемых лиц есть определенные права, установленные законодательством.
Например, инспектора могут запрашивать документы, отбирать пробы для анализов. А проверяемые вправе присутствовать при проверке, давать объяснения, обжаловать действия проверяющих.
Услуги СЭС для населения
Помимо контрольно-надзорной деятельности, СЭС оказывает населению и организациям различные платные услуги:
- Дезинфекция, дезинсекция и дератизация помещений;
- Санитарно-гигиенические экспертизы;
- Лабораторные исследования;
- Медицинские осмотры и оформление медкнижек.
Эти услуги может заказать любое заинтересованное лицо или организация. Для этого следует обратиться в ближайшую СЭС.
Дезинфекция, дератизация и дезинсекция
Это наиболее востребованные услуги СЭС. Их проводят для уничтожения микробов, насекомых, грызунов в помещениях, транспорте, на открытых площадках. Позволяют обеззаразить среду и предотвратить распространение инфекций.
Санитарно-гигиенические экспертизы
СЭС выдает заключения о соответствии продукции, проектов нормативным требованиям, условий труда гигиеническим нормам. Это необходимо для получения разрешений на производство, строительство и т.п.
Лабораторные исследования
Лаборатории СЭС проводят микробиологические, санитарно-химические, радиологические исследования воды, воздуха, почвы, продуктов питания, смывов и др.
Медосмотры и оформление медкнижек
СЭС проводит обязательные медицинские осмотры определенных категорий работников и оформляет личные медицинские книжки.
Обучение и повышение квалификации
Санитарно-эпидемиологические станции также предоставляют образовательные услуги - проводят обучение и повышение квалификации специалистов в области гигиены, эпидемиологии, лабораторной диагностики.
Такие курсы необходимы для сотрудников медучреждений, предприятий пищевой промышленности, общественного питания, торговли, образования и других организаций.
Полезные советы по выбору услуг СЭС
При необходимости воспользоваться услугами СЭС рекомендуется:
- Уточнить, проводит ли конкретная СЭС нужную услугу;
- Сравнить цены в нескольких организациях;
- Обратить внимание на отзывы клиентов;
- Запросить копии лицензий и сертификатов.
Это поможет выбрать оптимальный вариант и получить качественную услугу по доступной цене.
Профилактика заболеваний и рекомендации СЭС
СЭС регулярно информирует население о мерах профилактики инфекционных и паразитарных заболеваний.
Профилактика кишечных инфекций и пищевых отравлений
Соблюдайте правила личной гигиены, мойте руки перед едой. Пейте бутилированную или кипяченую воду. Тщательно обрабатывайте продукты, овощи и фрукты. Проверяйте срок годности.
Профилактика вирусных инфекций, гриппа и ОРВИ
Избегайте контактов с больными людьми. Регулярно проветривайте и увлажняйте воздух в помещении. Ведите здоровый образ жизни, закаливайтесь.
Борьба с педикулезом и чесоткой
Регулярно осматривайте кожу и волосы. При обнаружении признаков обработайте пораженные места специальными средствами. Постирайте постельное белье.
Рекомендации СЭС по личной гигиене
СЭС напоминает о важности соблюдения правил личной гигиены:
- Ежедневно принимайте душ, регулярно мойте руки;
- Стирайте и гладьте белье, чаще убирайтесь в доме;
- Пользуйтесь индивидуальными предметами гигиены;
- При кашле и чихании прикрывайте рот и нос.
Соблюдение этих несложных правил поможет уберечь вас и окружающих от инфекций.

